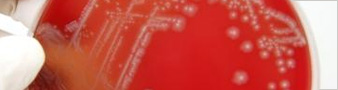
list red agar

- Home
-
Topics
- Accident and Dangerous Occurrence Reporting
- Accreditation
- Asbestos
- ATEX
- BeSMART.ie
- Biological Agents
- Brexit
- Bullying at Work
- Business Licensing and Notification Requirements
- Chemicals
- Classification and Labelling
- Complaint
- Confined Spaces
- Consultation
- Display Screen Equipment
- Education
- Electricity
- Employees Duties
- Ergonomics
- Explosives
- Fire
- First Aid
- Hazards
- Health and Safety Myths
- Horticulture
- Human Factors
- Illness Reports
- Inspections
- Liquid Petroleum Gas (LPG)
- Machinery
-
Managing Health and Safety
-
General Application Regulations 2007
- Display Screen Equipment
- Guide on Manual Handling Risk Assessment in the Retail Sector
- Guidance on the Manual Handling Training System - 2010 revision
- Guidelines on Hearing Checks and Audiometry Under the Safety, Health and Welfare at Work (General Application) Regulations 2007, Control of Noise at Work
- Safety, Health and Welfare at Work Act 2005
- Safety and Health Management Systems
- Safety Representatives and Consultation
- Safety Statement and Risk Assessment
-
General Application Regulations 2007
- Manual Handling
- Market Surveillance
- Motor Factors
- Personal Protective Equipment - PPE
- Physical Agents
- Posted Workers
- Prosecutions
- Public Consultation
- Radon
- Remote Working
- Safety Alerts
- Safety Representatives
- Signage
- Simple Safety
- Slips Trips Falls
-
Statistics
- Fatal Injury
- Non-Fatal Injury and Illness
-
Sector Statistics
- Agriculture, Forestry and Fishing
- Mining and Quarrying
- Manufacturing
- Electricity; Gas, Steam and Air Conditioning Supply
- Water Supply, Sewerage, Waste Management and Remediation Activities
- Construction
- Wholesale and Retail Trade; Repair of Motor Vehicles and Personal Goods
- Transportation and Storage
- Accommodation and Food Service Activities
- Information and Communication
- Financial and Insurance Activities
- Real Estate Activities
- Professional, Scientific and Technical Activities
- Administrative and Support Service Activities
- Public Administration and Defence; Compulsory Social Security
- Education
- Human Health and Social Work Activities
- Arts, Entertainment and Recreation
- Other Service Activities
- Annual Review of Workplace Injury, Illness and Fatality Statistics
- Other Statistical Reports
- European Statistics on Accidents at Work
- CSO Labour Force Survey Data
- Useful Links
- Calendar
- Sun Protection
- Ventilation
- Violence and Aggression
- Vulnerable Workers
- Welfare Payments
- Winter Readiness
- Work at Height
- Workplace Stress
- Work Related Vehicle Safety
- Work Safely
-
Your Industry
- ADR - Carriage of Dangerous Goods by Road
-
Agriculture & Forestry
- Overview
- Vehicles & Machinery
-
Livestock
- Working with Cattle
- Guidance on the Safe Handling of Cattle on Farms
- Safe Handling of Cattle on Farms Information Sheet
- Cattle Handling in Marts and Lairages
- Children's Book 'Stay Safe on the Farm with Jessy'
- Farm Safety During Lambing
- Sábháilteacht Feirme le linn Breith Uain
- Farm Safety During Calving
- Sábháilteacht Feirme le linn Breith Lao
-
Forestry
- Forestry Sector
- Using Petrol Driven Chainsaws
- Chainsaw Felling of Large trees
- Selecting & Monitoring of Contractors
- Mechanical Harvesting
- Extraction by Forwarders
- Electricity at Work
- Chainsaw Snedding
- Cross Cutting & Manual Stacking
- Chainsaw Clearance of Windblow
- Felling & Manual Takedown
- Chainsaw Safety Training Advice
- Forest Owners & Managers who intend to fell trees - Info Sheet
- Code of Practice for Managing Safety & Health in Forestry Operations
- Code of Practice for Managing Safety and Health in Forestry Operations
- Young & Older Persons on Farms
- Other Hazards
- Further Information
- BeSMART.ie
- Catering and Hospitality
-
Chemicals
-
Guidance & Support
-
Role Finder Tool
- Do you manufacture a substance?
- Do you distribute chemicals that you source from within the EU?
- Do you export chemicals to outside of the EU?
- Do you formulate mixtures using chemicals sourced from within the EU?
- Do you import articles from outside the EU?
- Do you import chemicals from outside the EU?
- Do you produce articles?
- Do you re-fill chemicals that you source from within the EU?
- Do you supply chemicals to another country within the EU?
- Do you use chemicals that you source from within the EU?
- Chemicals A-Z
- BeSmart Risk Assessment Tool
- Chemicals Act Guidance
- ECHA Guidance & FAQs
- ECHA Website
- Helpdesk Information
- Pesticides Control
- Poison Centre
-
Role Finder Tool
-
Legislation & Enforcement
- ADR - Carriage of Dangerous Goods by Road
- Asbestos
- The Chemicals Act
- Chemical Agents and Carcinogens
- Chemical Weapons
- Classification and Labelling
-
COMAH
- Overview
- Operator Information
-
Information to the Public
- Information to the Public
- List of Establishments
-
Lower Tier Establishments by Region
- Lower Tier Establishments in Dublin/Louth
- Lower Tier Establishments in Cork/Kerry
- Lower Tier Establishments in Clare/Limerick/Tipperary
- Lower Tier Establishments in Galway/Mayo/Sligo/Cavan/Roscommon
- Lower Tier Establishments in Offaly/Meath/Westmeath/Wicklow
- Lower Tier Establishments in Carlow/Waterford/Wexford
- Upper Tier Establishments by Region
- Emergency Planning
- Land Use Planning
- Guidance
- Forms
- Detergents
- Export/Import or PIC Regulation
- Nanomaterials
- REACH
-
Latest News
- ECHA’s RAC opinion and SEAC draft opinion on PFAS restriction published
- Have your say! 6 month consultation on SEAC draft opinion on PFAS restriction launched March 26th
- ECHA tutorial on how to claim notifier name as confidential
- New Detergents regulation has been published
- New! HSA e learning course on Obligations of EU Importers of Chemical Products under REACH and CLP
- One in five hazardous mixtures not reported to poison centres
- ECHA consults on recommending four substances for REACH authorisation
- Commission publishes note on the harmonised classification of titanium dioxide as Carcinogenic Category 2 via inhalation
-
Most Read
- Mandatory Training requirements for Professional and industrial users of Diisocyanates
- Selling chemical products online
- Poison Centre Notification
- Obligations for producers of candles/diffusers
- Safety Data Sheets
- Keep your registration up to date
- Chemical Risk Assessment
- Read the back
- REACH Authorisation List
- REACH Candidate List
- Paint containing MEKO
- Candles and reed diffusers containing LILIAL
- Public Consultations
-
Guidance & Support
- Construction
- Diving
- Docks
- Education
- Fishing
- Flammable Liquids and Fuels Retail Stores
-
Health and Social Care Sector
- The Health and Social Care Sector
- Health and Social Care Regulators
- Health and Social Care Illness and Injury Statistics
- Biological Agents
- Chemical Agents
- Electricity and Health and Social Care
- Manual Handling in Health and Social Care
- Slips, Trips and Falls in Health and Social Care
- Work Related Stress
- Violence and Aggression
- Work Equipment
- Occupational Hazards in Hospital Departments
- Occupational Hazards in Nursing Homes
- Mining
- Offshore
- Public Sector
-
Quarrying
- Health Surveillance Occupational Disease
-
Quarries in Ireland
- Quarry Accident and Inspection Statistics
- What to Expect from an Inspection
- HSA Quarry Sector Resources
- Safe Quarry Guidance
- Statutory Notifications
- Quarries Legislation and Guidance
-
New Quarries Regulations 2025 information
- Safety, Health and Welfare at Work (Quarries) Regulations 2025
- Summary of Amendments SHWW (Quarries Regulations) 2025
- Press Release: Minister Dillon signs Safety, Health and Welfare at Work (Quarries) Regulations 2025 into law
-
Frequently Asked Questions (FAQ’s) - Safety Health and Welfare at Work (Quarries) Regulations 2025
- When do the new regulations take effect?
- Which individuals and companies must comply with the Safety Health and Welfare at Work (Quarries) Regulations 2025?
- Are there new Definitions in the Safety Health and Welfare at Work (Quarries) Regulations 2025?
- Has the definition for a borrow pit changed?
- How should the appointment of a quarry manager be documented?
- Do I need to appoint a temporary quarry manager?
- Does the temporary quarry manager have to be competent?
- What should operators do to prepare for the appointment of a temporary quarry manager?
- Do I still need to notify the HSA of the appointment of a quarry operator?
- What if the cessation of my quarry operations is permanent?
- What if the cessation of my quarry operations is only temporary?
- I have already notified the HSA of the appointment of a quarry operator/common operator? Do I have to resubmit a form?
- How can I notify the HSA using an AFQ1 or AFQ2 form?
- Can I make an AFQ1 or AFQ2 notification online?
- I keep personal flotation devices on my quarry in case of an emergency in water, do I still need to inspect it regularly?
- Do I need to appoint a competent person to carry out drilling of shotholes for blasting activities?
- How do I ensure someone is competent to carry out drilling?
- Does the appointment of a competent driller have to be in writing?
- Do I need to update my shot firing rules?
- If any changes need to be made to the blast specification, what should I do?
- Do I have to keep records of Explosives and ANBI?
- How long should I keep records of geotechnical assessments carried out on my quarry?
- What about the air receivers’ section that was in Part 7 of the Safety Health and Welfare at Work (Quarries) Regulations 2008 Regulations?
- Events Organisations Publications
- Vehicle and Pedestrian Safety
- Quarry and Sand Pit Faces
- Drilling and Blasting
- Stockpiles Tips and Lagoons
- Maintenance Operations
- Crushing Sizing Screening
- Renewable Energy
- Retail
- Small Business
- Transport
- Chemicals
-
Legislation
-
Acts
- Safety, Health and Welfare at Work Act 2005
- Chemicals Acts 2008 and 2010
- Chemical Weapons Act 1997
- Organisation of Working Time Act 1997
- Safety Health and Welfare (Offshore Installations) Act 1987
- Safety in Industry Act 1980
- Dangerous Substances Act 1972
- European Communities Act 1972
- Factories Act 1955
-
Codes of Practice
- Code of Practice for Preventing Injury and Ill health in Agriculture
- Farm Safety Code of Practice - Risk Assessment document
- Code of Practice for the Design and Installation of Anchors
- Code of Practice for Working in Confined Spaces
- Working on Roads Code of Practice - for contractors with three or less employees
- Code of Practice for Avoiding Danger from Underground Services
- Code of Practice for Safety in Roofwork
- Code Of Practice for Biological Agents
- More Codes of Practice
-
Acts
-
Publications and Forms
- Online Complaint Form
- Forms
-
Publications
-
Agriculture
- Guidelines for safe working near overhead electricity lines in Agriculture
- Code of Practice on Preventing Accidents to Children and Young Persons in Agriculture
- Tractor Safety and You
- Guidance on the Safe Handling of Livestock at Marts and Lairages
- Cattle Handling in Marts and Lairages Information Sheet
- Safe Handling of Cattle on Farms
- Staying Fit for Farming
- Guidance on the Safe Use of Tractors and Machinery on Farms
- Health and Safety of Vets Visiting Farms
- Only a Giant Can Lift a Bull
- Farm Safety Action Plan 2016-2018
- Build in Safety - Advice for Farmers
- Working at Height in Agriculture Information Sheet
- Use Chemicals Safely on the Farm
- Risk Taking and Accidents on Irish Farms
- Risk Taking and Accidents on Irish Farms - Full Report
- Farm Safety Code of Practice - Risk Assessment Document
- Code of Practice for Preventing Injury and Occupational Ill Health in Agriculture
- Reducing the Risk of Back Injuries on the Farm
- Confined Spaces in Agriculture - Steps to Manage the Risks
- A Review of Work-Related Fatalities in Agriculture in Ireland 2011-2020
- Farm Safety Action Plan 2021-2024
- Farmers’ Health and Wellbeing
- Sláinte agus Folláine na bhFeirmeoirí
- How to Make Construction Appointments for Your Farm - Guidance
- Farm Safety During Lambing
- Farm Safety During Calving
- Sábháilteacht Feirme le linn Breith Uain
- Sábháilteacht Feirme le linn Breith Lao
- Guidance on Managing Fatigue with Farm Work
- Treoir maidir le Tuirse a Bhainistiú le hObair Feirme
- Farming in older age: Health in focus, safety in action
- Child Safety on the Farm Information Sheet
- Children and Safety on Farms
- Children's Book - Stay Safe on the Farm with Jessy
- Play Safe, Stay Safe on the Farm
- Health and Safety for Swine Workers
- Safety of Older Farmers
- Safe Handling of Cattle on Farms Information Sheet
- Working Safely with Bales on the Farm Information Sheet
- Quad Bike Safety Update
- Safe use of Quad Bikes in Agriculture and Forestry
- Safety for Seasonal Workers in Horticulture
- Conas Ceapacháin Tógála a dhéanamh do d'Fheirm
- Farm Safety Action Plan 2025 – 2027
-
As Gaeilge
- Programme of Work 2009 As Gaeilge
- Tuarascáil Bhliantúil an Údaráis Sábháilteachta agus Sláinte 2007
- Achoimre an HSA ar Staitisticí Gortaithe, Breoiteachta agus Báis 2006-2007
- Cairt Seirbhísí Chustaiméara
- An tÚdarás um Shábháilteacht agus Shláinte Clár Oibre 2007
- An tÚdarás Sláinte agus Sábháilteachta Ráiteas Straitéise 2007 2009
- Tuarascáil Bhliantúil 2005
- Tuairisc Bhliantuil 2004
- Tuairisc Bhliantuil 2003
- Tuarascáil Bhliantúil an Údaráis Sábháilteachta agus Sláinte 2008
- Achoimre an HSA ar Staitisticí Gortaithe, Breoiteachta agus Báis 2007-2008
- Ralteas Straiteise 2010-2012
- Cód Cleachtais le haghaidh Fostóirí agus Fostaithe maidir le Cosc agus Réiteach ar Bhulaíocht ag an Obair
- An Chairt Seirbhísí do Chustaiméirí
- Tionóiscí agus Tarluithe Contúirteacha san Ionad Oibre a Thuairisciú
- Treoir ar Shábháilteacht agus ar Shláinte Ghairme maidir le hOibrithe Leochaileacha san Ionad Oibre
- Ráiteas Straitéise 2025-2027
- Sláinte agus Folláine na bhFeirmeoirí
- Conas Ceapacháin Tógála a dhéanamh do d'Fheirm
- Sábháilteacht Feirme le linn Breith Uain
- Sábháilteacht Feirme le linn Breith Lao
- Treoir maidir le Tuirse a Bhainistiú le hObair Feirme
- Clar Oibre I 2010
- Annual Report Irish Version
- Annual Statistic Report Irish Version 2011
- Treoirlínte ar Bhainistiú Sábháilteachta, Sláinte agus Leasa i mBunscoileanna
- Tuarascáil Bhliantúil 2012
- Achoimre ar Staitisticí Báis, Breoiteachta agus Gortú sa Láthair Oibre 2011-2012
- Tuarascáil Bhliantúil 2019
- Safety for Seasonal Workers in Horticulture - Irish Version
- Tuarascáil Bhliantúil 2020
- Ráiteas Straitéise 2022-2024
- Clár Oibre 2022
- Tuarascáil Bhliantúil 2021
- Cód Cleachtais maidir le Cáilíocht Aeir Laistigh
- Measúnú Riosca Síceasóisialta — Nochtadh d'Ábhar Íogaire
- Athbhreithniú Bliantúil ar Ghortuithe, Tinnis agus Básanna san Ionad Oibre 2021-2022
- Treoir maidir le Sábháilteacht le Crocháin Ardaithe agus Irisí Othar i Suímh Shláinte agus Chúraim Shóisialta
- Tuarascáil ar an mBearna Phá idir na hInscní 2023
- Clár Oibre 2024
- Oibleagáidí táirgeoirí coinneal agus táirgeoirí idirleatóir giolcaí an AE
- Tuarascáil Bhliantúil 2023
- Allmhaireoirí Ceimiceacha Bileog Faisnéise
- Treoir Ghairid maidir le Faireachas Sláinte san Ionad Oibre
- Treoirlínte maidir le Garchabhair in Ionaid Oibre
- Tuarascáil Bhliantúil 2024
- Biological Agents
-
Chemical and Hazardous Substances
- Motor Vehicle Repair Information Sheet
- Motor Vehicle Repair Hazardous Chemicals
- CLP Poster 1 (A1 size) – Classification and Labelling Elements
- CLP Poster 2 (A1 size) – Hazard and Precautionary Statements
- CLP Poster 1 (A4 size) – Classification and Labelling elements
- CLP Poster 2 (A4 size) – Hazard and Precautionary Statements
- Chemical Safety Information Sheet
- Crystalline Silica Dust Information Sheet
- Dermal Exposure Information Sheet
- Epoxy Resins Information Sheet
- Isocyanates Information Sheet
- Machine Made Mineral Information Sheet
- Nanoparticles Information Sheet
- Respiratory Protective Equipment
- Your Steps to Chemical Safety
- Biological Monitoring Guidelines
- Storage of Hazardous Chemicals in Laboratories
- Storage of Hazardous Chemicals in Warehouses and Drum Stores
- Home Heating Oil Information Sheet
- Spray Polyurethane Foam SPF
- REACH Authorisation Information Sheet
- Export and Import of Chemicals Information Sheet
- 2012 Survey of Chemical Usage in Irish Workplaces
- Information for Retailers on Hazard Labelling & Packaging of Chemical Products
- Asbestos-containing Materials (ACMs) in Workplaces - Practical Guidelines on ACM Management and Abatement
- Asbestos Information Sheet
- Safety with Lead at Work
- Hazard Labelling & Packaging according to the CLP Regulation - Information Sheet
- Labelling and Packaging Requirements for Detergents & Biocidal Detergent Products
- A Guide to Non-Respiratory Personal Protective Equipment (PPE) for use with Chemical Agents in the Workplace
- Safe Working with Diesel Engine Exhaust Information Sheet
- Guidance for the Management of Household Hazardous Waste at Civic Amenity Sites
- Nail Bars Info Sheet
- 2018 Survey on Chemical Usage
- Chemical Agents and Carcinogens Code of Practice 2021
- Classification, Labelling & Packaging according to the CLP Regulation - Information Sheet
- Carriage of Dangerous Goods by Road 2021
- ADR Quick Reference Guide
- Retailers Duties when Selling Chemical Products
- Risk Assessment of Chemical Hazards
- Guidance on Technical Land Use Planning Advice
- Chemical Safety at Home and in the Garden
- Úsáid Ceimiceáin go Sábháilte sa Bhaile agus sa Ghairdín
- Use Chemicals Safely - Read the Label
- Safety Data Sheets for Hazardous Chemicals Information Sheet
- Obligations of EU candle and reed diffuser producers under REACH and CLP
- Chemicals Importer Information Sheet
- Poison Centre Notifications for Hazardous Chemical Mixtures in Ireland
- Storage of Hazardous Chemicals Information Sheet
- Carbon Monoxide Information Sheet
- Information for Retailers on Hazard Labelling & Packaging of Chemical Products (1)
- Use Chemicals Safely on the Farm
- Oibleagáidí táirgeoirí coinneal agus táirgeoirí idirleatóir giolcaí an AE
- Allmhaireoirí Ceimiceacha Bileog Faisnéise
- Safety Data Sheet (SDS) Information Sheet
- Chemical Distributors Duties REACH and CLP
- Safety in Contract Cleaning
- Local Exhaust Ventilation (LEV) Guidance
- Chemical Safety in the Workplace 2 - Online Course
- Communicating Chemical Hazards at Work Information Sheet
- Use Chemicals Safely on Building Sites
- Brexit Overview Information Sheet
- Chemicals in Further Education and Training (FET)
- Use Chemicals Safely in Schools
- Emergency Response Plans for Petrol Stations
- Storage of Hazardous Chemicals in Warehouses
- Chemical Agents Risk Assessment Template
- Chemical Inventory Template
- Chemical Agents Risk Assessment Template - Supporting Information
-
Codes of Practice
- 2025 Code of Practice for the Safety, Health and Welfare at Work (Exposure to Asbestos) Regulations, 2006-2025
- Code of Practice: Safe Use of Industrial Trucks
- Code of Practice for Rider-Operated Lift Trucks: Operator Training and Supplementary Guidance
- Code of Practice for Managing Safety and Health in Forestry Operations
- Code of Practice for Avoiding Danger from Underground Services
- Code of Practice for Access and Working Scaffolds
- Code Of Practice for Safety In Roofwork
- Code of Practice for Electrical Safety in Quarries
- Biological Agents Code of Practice 2020
- Chemical Agents Code of Practice 2024
- Cód Cleachtais maidir le Cáilíocht Aeir Laistigh
- Code of Practice for Indoor Air Quality
- Code of Practice for Employers and Employees on the Prevention and Resolution of Bullying at Work
- Chemical Agents Code of Practice 2020
- Code of Practice For Inland Diving and Inshore Diving
- Code of Practice for Offshore Diving
- Code of Practice for Avoiding Danger from Overhead Electricity Lines
- Code of Practice for Preventing Injury and Occupational Ill Health in Agriculture
- Farm Safety Code of Practice - Risk Assessment Document
- Code of Practice for the Design and Installation of Anchors
- Code of Practice for Working in Confined Spaces
- Code of Practice for Health and Safety in Dock Work
- COP for the Operators of Quarry Delivery Vehicles Employing 3 or less
- Children and Young Persons in Agriculture Code of Practice
- Code of Practice - For Contractors with Three or Less Employees Working on Roads
-
Construction
- Site Dumper and 360 Excavator Pre-start Checks
- Safe Use of Site Dumpers on Construction Sites
- Definition of Construction Work
- Guide for Homeowners
- Guide for Contractors and Project Supervisors
- Grandad Built Our House
- Mobile Elevated Work Platforms
- Requirements for Construction Site Welfare Facilities
- Construction Safety Partnership Advisory Committee Plan 2017-2019
- Guidance on Safety in Concrete Pumping
- Review of Construction-Related Fatal Accidents in Ireland 89-16
- Construction Site Traffic Management Plan (CSTMP) Guidance
- Construction Site Traffic Management Plan (CSTMP) Forms
- Construction Safety Action Plan 2022 - 2024
- Risk Assessment Method Statement (RAMS) Guidance Document
- Risk Assessment Method Statement (RAMS) Interactive Template
- Bileog Eolais D’Fhostaithe Deannach Silice 2023
- HSA Silica Leaflet - Czech
- HSA Silica Poster A3 - Czech
- HSA Silica Poster A3 - Lithuanian
- HSA Silica Leaflet - Lithuanian
- HSA Silica Poster A3 - Polish
- HSA Silica Leaflet - Polish
- HSA Silica Poster A3 - Portuguese
- HSA Silica Leaflet - Portuguese
- HSA Silica Poster A3 - Romanian
- HSA Silica Leaflet - Romanian
- HSA Silica Poster A3 - Russian
- HSA Silica Leaflet - Russian
- Summary of Key Duties under the Procurement, Design and Site Management Requirements of the Safety Health and Welfare at Work (Construction) Regulations, 2013
- Guidelines on the Procurement, Design and Management Requirements of the Safety health and Welfare at Work (Construction) Regulations 2013 (Updated)
- Lighten the Load for the Construction Sector
- Irish and Non-Irish National Construction Workers – Is There Really a Difference?
- Irish and Non-Irish National Construction Workers – Research on Differences in Approach to Health and Safety at Work
- Working on Roads Guidelines
- Understanding Construction Risk Assessment
- Manual Handling in the Irish Construction Industry - Summary Report
- Crystalline Silica Dust Information Sheet
- Asbestos-containing Materials (ACMs) in Workplaces - Practical Guidelines on ACM Management and Abatement
- Asbestos Information Sheet
- Use Chemicals Safely on Building Sites
- Code of Practice for Working in Confined Spaces
- Code of Practice for the Design and Installation of Anchors
- Code Of Practice for Safety In Roofwork
- Code of Practice for Avoiding Danger from Overhead Electricity Lines
- Code of Practice for Access and Working Scaffolds
- Code of Practice for Avoiding Danger from Underground Services
- Code of Practice - For Contractors with Three or Less Employees Working on Roads
- An Introduction to the Management of Manual Handling in the Construction Sector
- Reducing the Manual Handling of Roof Panels
- Reducing the Manual Handling of Glazing Units - Information Sheet
- Plain English Construction-Related Fatal Accidents in Ireland '89-'16
- High Visibility Clothing for Use Around Moving Vehicles
- Construction Safety Action Plan 2025 – 2027
-
Corporate
- Programme of Work 2026
- Climate Action Roadmap 2025
- Annual Review of Workplace Injuries, Illnesses and Fatalities 2023–2024
- Gender Pay Gap Report 2025
- Annual Report 2024
- HSA Annual Review of Workplace Injuries, Illnesses and Fatalities 2022
- Annual Report 2022
- Tuarascáil Bhliantúil 2022
- HSA Annual Review of Workplace Injuries, Illnesses and Fatalities 2022 (1)
- Ráiteas Straitéise 2025-2027
- Ralteas Straiteise 2010-2012
- Health and Social Care Advisory Committee (HSCAC) Action Plan 2025 – 2027
- Climate Action Roadmap 2024
- Clár Oibre 2025
- Programme of Work 2025
- Gender Pay Gap Report 2024
- Annual Review of Workplace Injuries, Illnesses and Fatalities 2022–2023
- Strategy Statement 2025-2027
- Tuarascáil Bhliantúil 2023
- Annual Report 2023
- Why a Health and Safety Inspector Calls to your Workplace
- Clár Oibre 2024
- Programme of Work 2024
- Tuarascáil ar an mBearna Phá idir na hInscní 2023
- Athbhreithniú Bliantúil ar Ghortuithe, Tinnis agus Básanna san Ionad Oibre 2021-2022
- Annual Review of Workplace Injuries, Illnesses and Fatalities 2021-2022
- Customer Action Plan
- Clár Oibre 2023
- Programme of Work 2023
- Annual Report 2021
- Tuarascáil Bhliantúil 2021
- Customer Service Charter
- Strategy Statement 2022-2024
- Programme of Work 2022
- Clár Oibre 2022
- Ráiteas Straitéise 2022-2024
- Tuarascáil Bhliantúil 2020
- HSA Annual Report 2020
- Annual Review of Workplace Injuries, Illnesses and Fatalities 2019–2020
- Programme of Work 2021
- Annual Review of Workplace Injury, Illness and Fatality Statistics, 2018-2019
- Tuarascáil Bhliantúil 2019
- Annual Report 2019
- Programme of Work 2020
- Summary of Workplace Injury, Illness and Fatality Statistics 2017 - 2018
- The Ageing Workforce In Ireland -Working Conditions, Health and Extending Working Lives
- Annual Report 2018
- Plain English Construction-Related Fatal Accidents in Ireland '89-'16
- Programme of Work 2019
- Strategy Statement 2019-21
- Statistics Report 2017
- Annual Report 2017
- Work-related Musculoskeletal Disorders, and Stress, Anxiety and Depression in Ireland - Evidence from the QNHS 2002–2013
- Trends and Patterns in Occupational Health and Safety in Ireland
- Research Programme on Health Safety and wellbeing at Work - Transport and Storage Sector (Plain English)
- Research Programme on Health Safety and wellbeing at Work - Transport and Storage Sector
- Research Programme on Health Safety and wellbeing at Work - Industry Sector (Plain English)
- Research Programme on Health Safety and wellbeing at Work - Industry Sector
- Research Programme on Health Safety and wellbeing at Work - Health Sector (Plain English)
- Research Programme on Health Safety and wellbeing at Work - Health Sector
- Research Programme on Health Safety and wellbeing at Work - Construction Sector (Plain English)
- Research Programme on Health Safety and wellbeing at Work - Construction Sector
- Research Programme on Health Safety and wellbeing at Work - Agriculture, Forestry & Fishing
- Research Programme on Health Safety and wellbeing at Work - Agriculture, Forestry & Fishing (Plain English)
- Programme of Work 2018
- Statistics Report 2016
- Annual Report 2016
- Programme of Work 2017
- ESRI Research Series Number 53
- Annual Report 2015
- Statistics Report 2015
- Strategy Statement 2016-2018
- Programme of Work 2016
- Annual Report 2014
- Statistics Report 2014
- Programme of Work 2015
- Annual Report 2013
- Statistics Report 2013
- Programme of Work 2014
- Ráiteas Straitéise 2013-2015
- Achoimre ar Staitisticí Báis, Breoiteachta agus Gortú sa Láthair Oibre 2011-2012
- Tuarascáil Bhliantúil 2012
- Statistics Report 2012
- Annual Report 2012
- Programme of Work 2013
- Strategy Statement 2013
- Financial Statements 2011
- Annual Report English Version 2011
- Annual Statistic Report Irish Version 2011
- Annual Report Irish Version
- Summary of Workplace Injury, Illness and Fatality Statistics 2010-2011
- Program of Work 2012
- Achoimre ar Staitisticí Báis, Breoiteachta agus Gortú sa Láthair Oibre 2009-2010
- Tuarascáil Bhliantúil 2010
- Summary of Workplace Injury Illness and Fatality Statistics 2009 2010
- Annual Report 2010
- Programme of Work 2011
- Summary of Workplace Injury, Illness and Fatality Statistics 2008-09
- Annual Report 2009
- Clar Oibre I 2010
- Strategy Statement 2010 - 2012
- Programme of Work 2010
- Annual Report 2003
- Annual Report 2004
- HSA Gender Pay Gap Report 2023
- Annual Report 2006
- Corporate Plan 2003-2007
- Health and Safety at Work in Ireland 1992 - 2002
- Summary of the Health and Safety at Work in Ireland 1992 - 2002 Report
- Summary of Fatality, Injury and Illness Statistics 2003 - 2004
- Summary of Fatality, Injury and Illness Statistics 2004 - 2005
- Strategy Statement 2007 - 2009
- Summary of Injury, Illness and Fatality Statistics 2005-2006
- Programme of Work 2007
- Programme of Work 2008
- Annual Report 2007
- Summary of Workplace Injury, Illness and Fatality Statistics 2006-2007
- Programme of Work 2009
- Summary of Workplace Injury, Illness and Fatality Statistics 2007-08
- Annual Report 2008
- Achoimre an HSA ar Staitisticí Gortaithe Breoiteachta agus Báis 2006-2007
- Tuarascáil Bhliantúil an Údaráis Sábháilteachta agus Sláinte 2007
- Diving
- Docks and Ports
-
Education
- Safety at Work - Accident Report (3rd Edition) (2007)
- Guidelines on Managing Safety, Health and Welfare in Primary Schools
- Guidelines on Managing Safety, Health and Welfare in Primary Schools - Short Guide
- Your Safety, Health and Welfare in Healthcare - Online Course
- Choose Safety Teachers' Text
- Choose Safety Students' Workbook
- Only a Giant Can Lift a Bull
- Treoirlínte ar Bhainistiú Sábháilteachta, Sláinte agus Leasa i mBunscoileanna
- Chemical Safety in the Workplace 2 - Online Course
- Chemicals in Further Education and Training (FET)
- Use Chemicals Safely in Schools
- Grandad Built Our House
- Too Cold for Sharks
- Fishing
-
Forestry
- Forestry Information Sheet
- Using Petrol-Driven Chainsaws - IFSG 301
- Chainsaw Felling of Large Trees - IFSG 307
- Selecting and Monitoring Contractors - IFSG FC1
- Mechanical Harvesting - IFSG 603
- Extraction by Forwarder - IFSG 503
- Electricity at Work - IFSG 804
- Chainsaw Snedding - IFSG 303
- Cross Cutting and Manual Stacking - IFSG 304
- Chainsaw Clearance of Windblow - IFSG 306
- Felling and Manual Takedown - IFSG 302
- Guidance on Safe Use of Chainsaws
- Quad Bike Safety Update
- Safe use of Quad Bikes in Agriculture and Forestry
- Chainsaw Safety Training Advice Information Sheet
- Safe Load Securing of Round Timber Information Sheet
-
General Application Regulations
- Control of Noise
- Safety Signs at a Place Work
- General Application Amendment Regulations Pressure Systems
- Guide to the Safety, Health and Welfare at (Work General Application) Regulations 2007
- Workplace
- Use of Work Equipment
- Personal Protective Equipment
- Manual Handling of Loads
- Display Screen Equipment
- Electricity
- Work at Height
- Control of Vibration at Work
- Protection of Children and Young Persons
- Protection of Pregnant, Post Natal and Breastfeeding Employees
- Night Work and Shift Work
- Explosive Atmospheres at Places of Work
-
Health and Social Care Sector
- Guide to the European Union (Prevention of Sharps Injuries in the Healthcare Sector) Regulations 2014
- Controlling Waste Anaesthetic Gases in Healthcare Settings
- Review of the HSA Five-Year Plan for the Healthcare Sector 2010-2014
- Guidance on Occupational Hazards in Dentistry
- Occupational Safety and Health and Home Care
- Guidance on Safety with Patient Hoists and Slings in Health and Social Care Settings
- Guidance on Managing the Risk of Lone Working in the Health and Social Care Sector
- Treoir maidir leis an Riosca a Bhaineann le hObair Aonair a Bhainistiú in Earnáil na Sláinte agus an Chúraim Shóisialta
- A Short Guide to Managing Health and Safety at Work in the Health and Social Care Sector
- Treoir maidir le Sábháilteacht le Crocháin Ardaithe agus Irisí Othar i Suímh Shláinte agus Chúraim Shóisialta
- Safety in Contract Cleaning
- Guidance on the Management of Manual Handling in Healthcare
- Health and Safety at Work in Residential Care Facilities
- Guidelines on Hearing Checks and Audiometry in the Workplace
- Safety Consultation and Representation in Health and Social Care
- Managing the Risk of Work-related Violence and Aggression in Health and Social Care
- Health and Social Care Advisory Committee (HSCAC) Action Plan 2025 – 2027
-
Horticulture
- Safety for Seasonal Workers in Horticulture - Belarusian
- Safety for Seasonal Workers in Horticulture - Bulgarian
- Safety for Seasonal Workers in Horticulture - Latvian
- Safety for Seasonal Workers in Horticulture - Lithuanian
- Safety for Seasonal Workers in Horticulture - Polish
- Safety for Seasonal Workers in Horticulture - Portuguese
- Safety for Seasonal Workers in Horticulture - Romanian
- Safety for Seasonal Workers in Horticulture - Russian
- Safety for Seasonal Workers in Horticulture - Thai
- Safety for Seasonal Workers in Horticulture - Ukrainian
- Safety for Seasonal Workers in Horticulture
- Safety for Seasonal Workers in Horticulture - Irish Version
-
Information Sheets
- Coffee Machines Thorough Examination Requirements
- Reporting Workplace Accidents and Dangerous Occurrences
- Vulnerable Workers Information Sheet
- Sound Matters - Occupational Noise
- Managing Driving for Work: Managing Grey Fleet
- Managing Driving for Work: My Responsibilities
- SunSmart Employee Information Sheet
- Safe Motor Vehicle Repair and Maintenance - Info Sheet
- Managing Grey Fleet Information Sheet
- Identifying Significant Hazards in Quarries - Information Sheet
- Guarding of Return Idler Rollers on Conveyors at Quarries - Information Sheet
- Fall Protection at the Top of the Quarry Face - Information Sheet
- Safe Load Securing of Site Cabins and Prefabs Information Sheet
- Safe Load Securing on Curtain-sided Vehicles Information Sheet
- Occupational Hygiene Report Writing Information Sheet
- Intoxicants at Work Information Sheet
- Work Related Stress Information Sheet for Employees
- Work Transport Safety - Falls from Vehicles
- Controlling Waste Anaesthetic Gases in Healthcare Settings
- Safe Load Securing of Round Timber Information Sheet
- Forestry Information Sheet
- Why a Health and Safety Inspector Calls to your Workplace
- Reducing the Manual Handling of Glazing Units - Information Sheet
- Classification, Labelling and Packaging (CLP) of Substances and Mixtures under EU CLP Regulation
- Chemicals Importer Information Sheet
- Obligations of EU candle and reed diffuser producers under REACH and CLP
- Labelling and Packaging Requirements for Detergents & Biocidal Detergent Products
- Hazard Labelling & Packaging according to the CLP Regulation - Information Sheet
- Information for Retailers on Hazard Labelling & Packaging of Chemical Products
- Export and Import of Chemicals Information Sheet
- Spray Polyurethane Foam SPF
- Home Heating Oil Information Sheet
- Storage of Hazardous Chemicals in Warehouses and Drum Stores
- Storage of Hazardous Chemicals in Laboratories
- Nanoparticles Information Sheet
- Machine Made Mineral Information Sheet
- Isocyanates Information Sheet
- Epoxy Resins Information Sheet
- Dermal Exposure Information Sheet
- Crystalline Silica Dust Information Sheet
- Chemical Safety Information Sheet
- Motor Vehicle Repair Information Sheet
- Composting Information Sheet
- Tionóiscí agus Tarluithe Contúirteacha san Ionad Oibre a Thuairisciú
- Health and Safety for Swine Workers
- Working at Height in Agriculture Information Sheet
- Guidance on the Safe Use of Tractors and Machinery on Farms
- Cattle Handling in Marts and Lairages Information Sheet
- Information for Retailers on Hazard Labelling & Packaging of Chemical Products (1)
- Safety on the Job for Apprentices
- Employing Apprentices: Safety on the Job
- Safety Data Sheet (SDS) Information Sheet
- Fire Extinguisher - Safety Checks
- Safe Working with Diesel Engine Exhaust - Information Sheet
- Crystalline Silica Dust - Information Sheet
- Wood Working - Information Sheet
- Chemical Distributors Duties REACH and CLP
- Working Safely with Bales on the Farm Information Sheet
- Safe Vehicle Tailboard Goods Lift Operations
- Quarry Vehicle Brakes Maintenance & Testing Info Sheet
- Chemical Safety in Hairdressing Information Sheet
- Brexit Overview Information Sheet
- Safe Lorry Loader Crane Operations Information Sheet
- Safe use of Quad Bikes in Agriculture and Forestry
- Quad Bike Safety Update
- The Health and Occupation Research Network Information Sheet
- Communicating Chemical Hazards at Work Information Sheet
- Choosing Slip-resistant Footwear - Information Sheet
- Preventing Slips, Trips and Falls at Work - Information Sheet
- Safer Work Stairs and Steps Information Sheet
- Becoming a Safety Representative or Joining the Safety Committee
- Managing Driving for Work Information Sheet
- Watch Your Step - Preventing Vehicle Related Slips, Trips and Falls Information Sheet
- Manual Handling Risk Reduction for the Transport and Logistics Sector
- Safe Load Securing of Precast Concrete Loads
- Safe Load Securing of Structural Steel Loads
- Safe Load Securing of Plant and Machinery
- Chainsaw Safety Training Advice Information Sheet
- Guidance-Note on Periodic Inspection and Testing of Electrical Installations
- Managing the Risk of Work-related Violence and Aggression in Healthcare Information Sheet
- Pedestrian Safety in the Workplace Information Sheet
- Forklift Safety Tips Information Sheet
- Forklift Operator Pre-Checks Information Sheet
- Delivering Safely Information Sheet
- Noise in Entertainment 2012
- Guidance on the Purchase of New Machinery Jan 2012
- Safety and Health Signs Information Sheet
- Safe Handling of Cattle on Farms Information Sheet
- Load Security Information Sheet
- Market Surveillance and the Health and Safety Authority
- A Resource List for Schools
- Workplace Transport Safety Reversing Vehicles
- Emergency Response Plans for Petrol Stations
- Using Ladders Safely - Information Sheet
- Safe Use of Work Platform / Trestles - Information Sheet
- Carbon Monoxide Information Sheet
- Explosives in Construction
- Child Safety on the Farm Information Sheet
- Machinery and Work Equipment
-
Manual Handling and Ergonomics
- Ergonomics in the Workplace
- Guidance on the Management of Manual Handling in the Workplace
- Guide on Prevention and Management of Musculoskeletal Disorders (MSDs)
- Guide on Manual Handling Risk Assessment in the Hospitality Sector
- Reducing the Risk of Back Injuries on the Farm
- Farm Safety During Lambing
- An Introduction to the Management of Manual Handling in the Construction Sector
- Reducing the Manual Handling of Roof Panels
- Reducing the Manual Handling of Glazing Units - Information Sheet
- Guidance on the Management of Manual Handling in Healthcare
- Guide on the Prevention of Upper Limb Disorders (ULDs) in the Financial Sector
- Guide on Manual Handling Risk Assessment in the Manufacturing Sector
- Guide on Manual Handling Risk Management in Transport and Storage
- Ergonomics - Good Practice in the Irish Workplace
- Managing Ergonomic Risk in the Workplace to Improve Musculoskeletal Health
- Risk Assessment for Managing Ergonomic Risks
- Guidance on the Manual Handling Training System - 2010 revision
- Guide on Manual Handling Risk Assessment in the Retail Sector
-
Mines and Quarries
- Guidance on Managing Stockpiles in the Quarry Industry
- Summary of Amendments to SHWW (Quarries Regulations) 2025
- Safety, Health and Welfare at Work (Quarries) Regulations 2025
- Quarry Vehicle Brakes Maintenance & Testing Info Sheet
- Safe Quarry - A Guide to Pedestrian Safety in Quarries
- Safe Quarry - Guidelines to the Safety, Health and Welfare at Work (Quarry) Regulations 2008
- Safe Quarry - A Guide for Quarry Workers
- Identifying Significant Hazards in Quarries - Information Sheet
- Guarding of Return Idler Rollers on Conveyors at Quarries - Information Sheet
- Fall Protection at the Top of the Quarry Face - Information Sheet
- COP for the Operators of Quarry Delivery Vehicles Employing 3 or less
- Code of Practice for Electrical Safety in Quarries
- Guidance on the Safe Use of Explosives in Quarries
- Guidance For Carrying Out Risk Assessment at Surface Mining Operations
- Guidance to Ensure Safe Use of Large Vehicles and Earth-moving Equipment in Quarries
-
Occupational Health
- Guidelines on Hearing Checks and Audiometry Under the Safety, Health and Welfare at Work (General Application) Regulations 2007, Control of Noise at Work
- Occupational Safety and Health Guidance on Vulnerable Workers in the Workplace
- Driving for Work - Driver Health Guidelines
- Workplace Health Toolkit for Small Businesses
- Vulnerable Workers Information Sheet
- The Health and Occupation Research Network Information Sheet
- Treoir maidir leis an Riosca a Bhaineann le hObair Aonair a Bhainistiú in Earnáil na Sláinte agus an Chúraim Shóisialta
- Guidance on Managing the Risk of Lone Working in the Health and Social Care Sector
- Code of Practice for Indoor Air Quality
- Treoir ar Shábháilteacht agus ar Shláinte Ghairme maidir le hOibrithe Leochaileacha san Ionad Oibre
- Cód Cleachtais maidir le Cáilíocht Aeir Laistigh
- Guidance on the New Manual Handling Training System
- A Short Guide to Health Surveillance in the Workplace
- Treoir Ghairid maidir le Faireachas Sláinte san Ionad Oibre
- Guidelines on First-Aid at Places of Work
- Treoirlínte maidir le Garchabhair in Ionaid Oibre
- Guidance on Managing the Risk of Work-Related Violence and Aggression
- Measúnú Riosca Síceasóisialta — Nochtadh d'Ábhar Íogaire
- Exposure to Sensitive Content Risk Assessment Template
- Psychosocial Risk Assessment: Guidance for Exposure to Sensitive Content
- Managing Psychosocial Hazards in the Workplace 2023
- ROI THOR 2019 annual report
- ROI THOR 2019 annual report summary
- Occupational Hygiene Report Writing Information Sheet
- Local Exhaust Ventilation (LEV) Guidance
- Night and Shift Work 2012
- Intoxicants at Work Information Sheet
- Work Related Stress Information Sheet for Employees
- Work Related Stress A Guide for Employers
- Legionnaires' Disease Information Sheet
- Guidelines on Occupational Asthma
- A Review of the Occupational Diseases Reporting System in the Republic of Ireland
- The Noise of Music
- Guidelines on Occupational Dermatitis
- Report of the Task Force on the Prevention of Workplace Bullying
- Employees with Disabilities
-
Physical Agents
- Guidelines on Hearing Checks and Audiometry in the Workplace
- Guidelines on Hearing Checks and Audiometry Under the Safety, Health and Welfare at Work (General Application) Regulations 2007, Control of Noise at Work
- The Noise of Music
- Noise in Entertainment 2012
- Control of Noise
- Sound Matters - Occupational Noise
- Guide to the Electromagnetic Fields Regulations 2016
- Electromagnetic Fields - Volume 2: Case Studies
- Electromagnetic Fields - Volume 1: Practical Guide
- Electromagnetic Fields - Guide for SMEs
- Artificial Optical Radiation at Work Regulations 2010
-
Research Publications
- Cost of Workplace Accidents - 2005 Report
- Fatal accidents in the Irish construction industry 1991-2001: A survey of contributory factors
- The costs and effects of workplace accidents - Twenty case studies from Ireland
- An investigation into the official data sources and collection methods used to capture selected work-related death statistics in the Republic of Ireland
- An Examination of Duty Holder Responsibilities: Fatal Construction accidents 1997-2002
- An Assessment of the Cost of Reported Accidents in High-risk Workplaces
- Measuring the Impact of Health and Safety Interventions
- Analysis of the Causes and Costs of Manual Handling Incidents in the Health Care Sector
- Best Manual Handling Practices at Dublin Airport
- Best Manual Handling Practices at Dublin Airport - Executive Summary
- Survey on Inspections - 2003
- Communicating with Micro Businesses in the Mining and Quarrying Sector
- Feasibility Study on Estimation of Costs of Workplace Accidents, work-related ill-health and non-injury incidents in Ireland
- A Review of the Occupational Diseases Reporting System in the Republic of Ireland
- Safety Behaviour in the Construction Sector
- Exposure assessment to airborne contaminants in the indoor environment of Swine Farms
- Exposure assessment to airborne contaminants in the indoor environment of Swine Farms - Appendix
- The incidence of occupational skin and respiratory disease as reported to The Health and Occupation Reporting (THOR) network by physicians in the Irish Republic between 2005 and 2007
- Impact Assessment of the Working at Height Campaign in the Construction Sector
- Job Stress And Working Condition - Ireland In Comparative Perspective
- HSA Consumer View Survey
- Risk Taking and Accidents on Irish Farms
- Risk Taking and Accidents on Irish Farms - Full Report
- Review of Construction-Related Fatal Accidents in Ireland 89-16
- Trends and Patterns in Occupational Health and Safety in Ireland
- Research Programme on Health Safety and wellbeing at Work - Agriculture, Forestry & Fishing (Plain English)
- Research Programme on Health Safety and wellbeing at Work - Agriculture, Forestry & Fishing
- Research Programme on Health Safety and wellbeing at Work - Construction Sector
- Research Programme on Health Safety and wellbeing at Work - Construction Sector (Plain English)
- Research Programme on Health Safety and wellbeing at Work - Health Sector
- Research Programme on Health Safety and wellbeing at Work - Health Sector (Plain English)
- Research Programme on Health Safety and wellbeing at Work - Industry Sector
- Research Programme on Health Safety and wellbeing at Work - Industry Sector (Plain English)
- Research Programme on Health Safety and wellbeing at Work - Transport and Storage Sector
- Research Programme on Health Safety and wellbeing at Work - Transport and Storage Sector (Plain English)
- Work-related Musculoskeletal Disorders, and Stress, Anxiety and Depression in Ireland - Evidence from the QNHS 2002–2013
- Workplace Risks and Worker Outcomes in Ireland from a Comparative Perspective: An Analysis of the European Working Conditions Survey, 2005 and 2010
- Inspection Process Survey - Research Report
- Guide on Prevention and Management of Musculoskeletal Disorders (MSDs)
-
Retail
- Lighten the Load for the Retail Sector
- Safety Toolkit and Short Guide to General Application Regulations 2007 Small Business Edition
- Guidance on the Management of Manual Handling in the Workplace
- Guide to the Safety, Health and Welfare at (Work General Application) Regulations 2007
- Retailers Duties when Selling Chemical Products
- Information Sheet on Work-related Violence and Aggression in Retail
-
Safe System of Work Plan (SSWP)
- SSWP Building and Monument Maintenance Pictograms
- SSWP House Building Pictograms
- SSWP House Building Form
- SSWP Civil Engineering Pictograms
- SSWP Demolition Pictograms
- SSWP Demolition Form
- SSWP Ground Works Pictograms
- SSWP New Commercial Building Pictograms
- SSWP New Commerical Building Form
- SSWP Ground Works Form
- SSWP Roadworks Pictograms
- SSWP Roadworks Form
-
Safety and Health Management
- Safety Representatives Resource Book (eBook Version)
- Safety Representatives Resource Book (Print Version)
- Sample Risk Assessment – Work-related Violence and Aggression
- A Short Guide to Health Surveillance in the Workplace
- Guidelines on First-Aid at Places of Work
- Exposure to Sensitive Content Risk Assessment Template
- Psychosocial Risk Assessment: Guidance for Exposure to Sensitive Content
- Becoming a Safety Representative or Joining the Safety Committee
- A Short Guide to Managing Health and Safety at Work in the Health and Social Care Sector
- Guidance on Safety with Patient Hoists and Slings in Health and Social Care Settings
- Code of Practice for Indoor Air Quality
- Code of Practice for Employers and Employees on the Prevention and Resolution of Bullying at Work
- Code of Practice for Working in Confined Spaces
- Safety in Contract Cleaning
- Treoirlínte maidir le Garchabhair in Ionaid Oibre
- Treoir Ghairid maidir le Faireachas Sláinte san Ionad Oibre
- Treoir ar Shábháilteacht agus ar Shláinte Ghairme maidir le hOibrithe Leochaileacha san Ionad Oibre
- Cód Cleachtais maidir le Cáilíocht Aeir Laistigh
- Health and Safety for Swine Workers
- Health and Safety at Work in Residential Care Facilities
- Occupational Safety and Health Guidance on Vulnerable Workers in the Workplace
- Reporting Workplace Accidents and Dangerous Occurrences
- Vulnerable Workers Information Sheet
- SunSmart Employee Information Sheet
- Managing Hazards in the Workplace
- Employees with Disabilities
- A Guide to Maintaining Best Practices in Safety and Health (1)
- A Guide to Risk Assessments and Safety Statements
- Guidance on the Safety, Health and Welfare at Work (Reporting of Accidents and Dangerous Occurrences) Regulations 2016
- Safety Representatives and Safety Consultation Guidelines
- Behaviour Based Safety Guide
- Workplace Health Toolkit for Small Businesses
- A Strategy for the Prevention of Workplace Accidents, Injuries and Illnesses (2004-2009)
- A Short Guide to the Safety, Health and Welfare at Work Act 2005
- Guide to the Safety, Health and Welfare at Work Act, 2005
- Workplace Safety and Health Management
- A Guide to Maintaining Best Practices in Safety and Health
- Using Ladders Safely - Information Sheet
- Health and safety matters for students embarking on work experience - A short guide for teachers
- HSA Training Guidance Safety Representatives
-
Slips Trips and Falls
- Choosing Slip-resistant Footwear - Information Sheet
- Preventing Slips, Trips and Falls at Work - Information Sheet
- Safer Work Stairs and Steps Information Sheet
- Watch Your Step - Preventing Vehicle Related Slips, Trips and Falls Information Sheet
- Slips Trips and Falls Mapping Tool
- Safety in Licensed Premises Case Study - Slips, Trips and Falls
-
Work Related Vehicles
- Workplace Transport Checklist
- Workplace Transport Safety - Safe Workplace
- Workplace Transport Safety Safe Driver
- Workplace Transport Safety Safe Vehicle
- Workplace Transport Safety Management Information Sheet
- Safe Driving for Work Employer Guide
- Transport Risk Assessment Sheet
- Work Related Vehicle Safety Five Year Plan
- Watch Out Traffic About Posters
- Vehicle Safety Check Posters
- Moving Goods Poster
- Van Driver Walk Around Check Sheet
- Bus Driver Walk Around Check Sheet
- HGV Driver Walk Around Check Sheet
- Load Security Information Sheet
- Forklift Truck Operator Pre Use Checklist and Poster
- Forklift Truck Operator Checklist and Poster
- Safe Driving for Work Handbook
- Skip Lorry Safety Checklist and Poster
- Tractor Safety and You
- Safe use of Quad Bikes in Agriculture and Forestry
- Motor Vehicle Repair Information Sheet
- Code of Practice - For Contractors with Three or Less Employees Working on Roads
- Code of Practice for Rider-Operated Lift Trucks: Operator Training and Supplementary Guidance
- High Visibility Clothing for Use Around Moving Vehicles
- Safe Load Securing of Round Timber Information Sheet
- Workplace Transport Safety Reversing Vehicles
- Work Transport Safety - Falls from Vehicles
- Delivering Safely Information Sheet
- Forklift Operator Pre-Checks Information Sheet
- Forklift Safety Tips Information Sheet
- Pedestrian Safety in the Workplace Information Sheet
- Safe Load Securing of Plant and Machinery
- Safe Load Securing of Structural Steel Loads
- Safe Load Securing of Precast Concrete Loads
- Manual Handling Risk Reduction for the Transport and Logistics Sector
- Watch Your Step - Preventing Vehicle Related Slips, Trips and Falls Information Sheet
- Managing Driving for Work Information Sheet
- Safe Load Securing on Curtain-sided Vehicles Information Sheet
- Safe Load Securing of Site Cabins and Prefabs Information Sheet
- Safe Lorry Loader Crane Operations Information Sheet
- Managing Grey Fleet Information Sheet
- Safe Vehicle Tailboard Goods Lift Operations
- Safe Motor Vehicle Repair and Maintenance - Info Sheet
- Managing Driving for Work: My Responsibilities
- Managing Driving for Work: Managing Grey Fleet
- Driving for Work - Driver Health Guidelines
- Guide on Manual Handling Risk Management in Transport and Storage
- Work Related Vehicle Safety Program Plan and Priorities for 2016-2018
- Work-Related Deaths Involving Vehicles in Ireland 2010–2019
- Skip Lorry Safety Information Sheet
- Skip Lorry Safety Checklist and Poster (1)
- RCV Inspection Campaign 2024 - Findings
-
Agriculture
- Safety Alerts
-
Employer and Employee Supports
- Health and Safety Basics for Small Businesses
- Digital Tools
- Small Business Resources
-
Safety Representatives
- Safety Representatives
- Consultation and Safety Representatives Survey 2024
- Beyond Compliance Podcast - Safety Representatives
- Safety Representative Information Video
- Training Requirements
- The Benefits of having a Safety Representative
- What are the Legal Requirements?
- What can a Safety Representative do?
- What Information must be Provided to a Safety Representative?
- Other Resources
- New Publications and Translated Resources
- Safety Promotion
- Impact Infographics
- Education
-
Vehicles at Work
-
Vehicles at Work Guidance & Resources
- COVID-19
- Docks
- Driving for Work
- Forklifts
- eLearning
- BeSMART.ie
- Manual Handling
- Vehicle Slips Trips & Falls
- Workplace Traffic Management
- Pedestrian Safety
- Load Securing
- Vehicle Operations
- A.D.R.
- Previous Transport Safety Seminars
- Vehicles in Agriculture
- Accident Reporting
- Vehicle Risks Case Studies
- HSA Events
- Transport YouTube channel
-
Work Related Vehicle Safety
- Work Related Vehicles Safety Program Plan and Priorities for 2016-2018
- Public Consultation on new Code of Practice - Safe Industrial Truck Operation
- Legal Requirements
- Vehicle Related Accident Trends
- Vehicle Risks
- How to Manage Work Related Road Risks
- Online Vehicle Risk Management Resource (EU Commission)
-
Driving for Work
- Winter Driving Tips
- Grey Fleet Driver Declaration Form
- Managing Grey Fleet Information Sheet
- HSA and UCD joint webinar on Work Related Road Fatalities
- Employer Responsibilities
- Online Course
- Driver Management
- Driving for Work Employers Guidelines
- Vehicle Safety Pre-Checks
- Vehicle Risk Management Business Case Studies
- Workplace Transport Safety
- Load Securing
- Working On or Near a Road
- Transport and Storage
-
Vehicles at Work Guidance & Resources
-
Workplace Health
- Accidents and Behaviour
- Bullying at Work
- Occupational Health
- Manual Handling & Display Screen Equipment
- Occupational Asthma and Dermatitis
- Sensitive Risk Groups
- Research Reports
- Workplace Stress
- Careers
-
News, Events & Media
-
Events
- HSA Webinars
-
Webinar Recordings
- Building a Resilient Safety Culture: Doing Safety Differently Webinar
- Design Work for People: Ergonomics and Human Factors Webinar
- Introduction to Managing Work-related Violence and Aggression: Guidance, Insights and Regulation
- Code of Practice: Safe Use of Industrial Trucks Webinar for Employers
- Code of Practice: Safe Use of Industrial Trucks Webinar for Trainers
- Optimising Performance, Minimising Error: The Role of Human Factors in Workplace Safety Webinar
- Mastering Psychosocial Risk Assessment with Work Positive Webinar
- New CLP Hazard Classes Webinar 2025
- Driving for Work Webinar 2024
- HSA Webinar: Influencing Safety Culture
- Ergonomics in the Irish Workplace: Risk Assessment to Manage Risk Exposure
- Webinar on Increasing Psychological Safety at Work
- Webinar on Reducing Interpersonal Conflict at Work
- Webinar: Practical Ergonomic Risk Assessment in Construction 2023
- Ergonomics and Psychosocial Webinar
- Guidance on Technical Land Use and Planning
- Land Use Planning around COMAH sites – Essential Information
- Ergonomics Webinar - EU-OSHA Lighten the Load Campaign '21
- IAF Informative and Mandatory Documents - Oct '21
- Practical Ergonomic Risk Assessment in Manufacturing - Oct '21
- Practical Ergonomic Risk Assessment in the Health Sector - Nov '21
- Practical Ergonomic Risk Assessment in Construction - Oct '21
- ISO/IEC 17020 and application of P 15 - Jun '21
- Working from Home: Managing Ergonomic and Psychosocial Hazards - May '21
- INAB Biobanking Webinar - April 23rd
- Notifying Hazardous Mixtures to the National Poisons Information Centre March 2021
- Ergonomics Webinar Series October 2020
- Brexit Webinar Series October 2020
- HSA Events 2026
-
Previous Events
- Preventing Common Workplace Injuries in Small Businesses - Cork
- Building a Resilient Safety Culture: Doing Safety Differently Webinar
- Code of Practice: Safe Use of Industrial Trucks Webinar for Employers
- Driving for Work Seminar: Safe Truck Fleet Operations - Fit for the Road
- Navigating the Human Impact of Digital Transformation - Seminar
- Optimising Performance, Minimising Error: The Role of Human Factors in Workplace Safety Webinar
- Mastering Psychosocial Risk Assessment with Work Positive Webinar
- New CLP Hazard Classes Webinar 2025
- Driving for Work Webinar 2024
- HSA Webinar: Influencing Safety Culture
- Smart Workplaces: AI, Robotics and Impact on Occupational Safety
- Safety Representatives National Conference 2024
- Managing Hidden Hazards: Human Behaviour at Work
- Webinar on Increasing Psychological Safety at Work
- Webinar on Reducing Interpersonal Conflict at Work
- Safe and Healthy Work in the Digital Age 2023
- EU Chemicals Strategy for Sustainability Conference 2023
- Webinar: Practical Ergonomic Risk Assessment in Construction 2023
- Workers' Memorial Day
-
News
-
Press Releases 2026
- Health and Safety Authority launches national safety drive to tackle leading cause of fatalities on farms
- Flanagan Concrete Products Limited fined €80,000 following fatal incident
- Meade Potato Company Unlimited fined €150,000 following an incident in which an employee’s arm was trapped in machinery
- ‘Falls are preventable’: New All-Island Construction Safety Campaign Begins
- New agreement allows HSA to deploy drones to assist in serious incident investigations
- HSA to launch national inspection campaign focusing on safe handling of livestock ahead of calving season
- Kildare Chilling Company fined €225,000 following a fatal accident on the 14th of May 2020
- Health and Safety Authority reports sharp rise in work-related fatalities in 2025
- Media Queries
- Newsletters & Bulletins
- European Union Senior Labour Inspectors Committee (SLIC)
- European Agency for Safety and Health at Work
-
Press Releases 2026
- Social Media
-
Archive
-
Press Releases 2013 to 2025
-
Press Releases 2025
- HSA targets sea fishing sector with a view to reducing high fatality rate
- HSA brings the 'Keep Safe' Roadshow to Donegal School Children
- Kildare company fined €75,000 after worker was struck and killed by rotating robotic arm
- HSA issues urgent safety reminder to farmers during busy silage season
- Employers and outdoor workers urged to reduce skin cancer risk by prioritising sun safety
- Health and Safety Authority begins quarry safety inspection campaign
- Health and Safety Authority urges caution with outdoor work following sharp rise in fatalities
- Call for Organisations to Support Safety Representatives on Workers’ Memorial Day
- Health and Safety Authority brings the Keep Safe Roadshow to Athlone School Children
- HSA launches national farm safety inspection campaign following 28 vehicle-related deaths in last five years
- Fines totalling €450,000 handed down following fatal injury to worker in Dublin Ferryport
- John Fletcher Limited fined €400,000 following death of employee in workplace incident
- Marine Terminals Limited fined €15,000 following a fatal incident at Dublin port
- Health and Safety Authority urges a safety first approach during storm clean-up
- HSA to launch inspection campaign focusing on the safe handling of livestock ahead of busy calving season
- Work-related fatalities rate in Ireland reaches record low in 2024
- HSA launches campaign to tackle silent killers on farms
- A safer blend to protect workers at Midleton Distillery wins prestigious European award
- HSA and ESB Networks join forces to promote electricity safety in the workplace
- Irish Packaging Recycling Unlimited Company fined €650,000 following fatal incident at Recycling Plant in Finglas
- All-island safety campaign targets deadly falls in construction and farming
- Health and Safety Authority announces appointment of Mark Cullen as new CEO
- Machinery, working at height and construction on farms in the spotlight as Health and Safety Authority returns to the National Ploughing Championships
- Health and Safety Authority targets forestry sector in new safety focus
- HSA calls for renewed commitment from farmers as Farm Safety Week begins
- Colas Contracting Ltd fined €270,000 following fatal incident during road resurfacing at Meetcon, Tarbert, Co. Kerry
- Health and Safety Authority publishes 2024 Annual Report highlighting strengthened enforcement, effective collaboration and targeted outreach programmes
- Health and Safety Authority secures High Court order prohibiting works at high-risk construction site in Kilcock, Co. Kildare
- Bellingham Farms Unlimited fined following fatal workplace incident in Co. Louth
- Director Brian Kelly, along with his company Solar Power BK Limited, fined and given suspended jail sentence, following death of employee in workplace incident
- New national action plan launched to safeguard construction workers across Ireland
- HSA, RSA and Gardaí issue new safety guidance to support safer driving for work
- New action plan to target high level of farm deaths and injuries unveiled
- Action plan to target worker health and safety in the health and social care sector launched
- Waterford Company fined €150,000 after worker struck and killed by large portion of masonry from a wall
- HSA launches inspection campaign focusing on silica dust in Construction
-
Press Releases 2024
- Health and Safety Authority reports 43 work-related fatalities in 2023
- Dairy farmer fined after fall from height leads to fatality on farm
- HSA launches inspection campaign focusing on livestock safety ahead of calving season
- HSA Urges Chainsaw Users to Put Safety First During Storm Clean Up
- Fines handed down following fatal incident at quarry
- Company fined €100,000 following death of worker
- Ministers Heydon and Richmond launch farm machinery safety awareness campaign
- New Chemical Agents Code of Practice published
- Dublin waste disposal company fined €60,000 following fatal accident
- HSA announce the establishment of a Health and Social Care Advisory Committee
- Agricultural contractor fined €65,000 after serious injury of farmer
- Workers Memorial Day event held in Garden of Remembrance
- Kildare business owners fined €175,000 after worker’s fatal fall from height
- HSA’s national farm safety inspection campaign now underway
- HSA launch two-week quarry safety inspection campaign
- Nitrofert Limited fined €350,000 following fatal accident
- The HSA bring the Keep Safe Roadshow to Oranmore school children
- Call for Entries: European Awards Recognise Innovative Workplace Safety and Health in the Digital Age
- The HSA remind outdoor workers and employers that sun protection is vital during summer months
- HSA publishes its 2023 Annual Report highlighting key achievements and outcomes across its broad and varied mandate
- Health and Safety Authority launches forestry inspection campaign
- HSA launch farm inspection campaign focusing on safe work at height
- HSA to focus on tractor safety and farmer’s health and wellbeing at this year’s National Ploughing Championships
- HSA launches two-week inspection campaign on safe machinery operations in quarries
- Health and Safety Authority brings the Keep Safe Roadshow to Tullamore school children
- HSA: Work-Related Violence Is Never "Part of the Job" - New Campaign Highlights Employers' Duty to Protect Workers
- HSA launches inspection campaign on construction sites to address dangers of working at height and ergonomics
- HSA to run inspection campaign focusing on health and wellbeing of farmers
- West Meath company fined €125,000 after incident involving worker falling from height
- The HSA bring the Keep Safe Roadshow to Bray school children
- Health and Safety Authority publishes its three year strategy to protect Irish workers, contribute to productive enterprises and strengthen compliance
-
Press Releases 2023
- HSA launches inspection campaign focusing on livestock handling safety
- Inisfallen Inns Ltd fined €50,000 following serious incident
- GP Wood Ltd fined €90,000
- HSA appoints Conor O’Brien as new Chief Executive Officer
- Farm Safety Partnership release Electrical Safety on Farms video
- Company fined €250,000 after fatal accident at Dublin Airport
- HSA to launch farm vehicle inspection campaign on Monday 17th April
- HSA and ATU launch free online Health and Safety Induction for SME’s
- Kildare company fined €55,000 following serious incident
- Ceremony Held to Mark Workers’ Memorial Day
- HSA to launch two week inspection blitz in quarries across Ireland
- Construction Worker handed down 9 months suspended jail sentence
- HSA launches two week inspection campaign in construction sector
- HSA launch guidance on the dangers of UV rays for outdoor workers
- Company fined €750,000 after fatal fall from height in workplace
- Employer sentenced to 12 months in prison after workplace fatality on Tipperary farm
- Tipperary company fined €75,000 after employee suffered serious injury in workplace
- Minister Richmond appoints Patricia Byron as Chairperson of the Health and Safety Authority
- Agricultural contractor fined €30,000 following fatal incident on farm
- The Health and Safety Authority and State Claims Agency publish joint guidance on occupational exposure to sensitive content
- HSA launch a two week quarries inspection campaign
- Health and Safety Authority Urges Farmers to Complete Training Ahead of New Quad Bike Regulations
- HSA begins two-week inspection campaign focusing on working at height in agriculture
- HSA begins inspection campaign focusing on renewable energy installations including wind farms
- Company fined €50,000 following fall from height
- HSA launches inspection campaign on health and wellbeing of farmers
- HSA launches two-week inspection campaign in construction sector
-
Press Releases 2022
- Damien English TD, launches the HSA’s Strategy Statement 2022 - 2024
- HSA launches inspection campaign focusing on livestock safety
- Kildare Chilling Company fined €400,000 following death of employee
- Irish Cement Ltd (ICL) fined €225,000 following injury of an employee.
- HSA launches inspection campaign to target transport operations and vehicles risks in Docks and Ports
- Construction Safety Partnership Advisory Committee launch Action Plan for 2022 – 2024
- Shabra Recycling Ltd fined €75,000 following fatal injury of employee
- HSA inspection campaign to target transport operations and vehicles at work
- HSA launches national Quarry Safety Inspection Campaign focusing on machinery safety
- HSA launch a farm vehicle inspection campaign in April 2022
- David Mulcahy Electrical Ltd fined €5,000 following incident at Paris Texas public house
- HSE fined €10,000 following guilty plea to ‘violence and aggression’ charges
- Health and Safety Authority and Irish Congress of Trade Unions commemorate Workers’ Memorial Day
- INAB Launches Ireland’s First Ever Accreditation Strategy
- HSA launch course for Seasonal Workers in Horticulture in 10 languages
- PWP Ltd plead guilty to breaches of health and safety legislation.
- HSA publishes Annual Report 2021
- Foilsíonn tÚdarás Sláinte agus Sábháilteachta Tuarascáil Bhliantúil 2021
- HSA launch Health and Wellbeing Guidance for farmers
- HSA urges farmers to get ready for new quad bike regulations
- HSA launch farm inspection campaign focusing on safe work at height
- HSA set to launch Quarry safety inspection campaign next week
- Palfinger Ireland Limited and Nationwide Crane Hire Limited fined
- Denis Moriarty The Kerries Limited fined €220,000
- HSA Annual Review of Workplace Injuries, Illnesses and Fatalities 2022
- HSA launches two week inspection campaign in construction sector
- Farm inspection campaign launched to focus on health and wellbeing
- HSA publish ambitious Programme of Work for 2023
- Drumderry Aggregate Limited fined €80,000 after fatal accident
- Health and Safety Authority confirms 26 work-related fatalities in 2022
- HSA Annual Review of Workplace Injuries, Illnesses and Fatalities 2022 (1)
- PWP Ltd plead guilty to breaches of health and safety legislation. (1)
-
Press Releases 2021
- Workplace Relations Commission / Health and Safety Authority Code of Practice for Employers and Employees on the Prevention and Resolution of Bullying at Work
- Jackson Engineering (Castlebar) Ltd fined €30,000 following life-changing injury to employee
- Tom Lynes Plant Hire Ltd fined €80,000 after on-site employee suffers serious injuries
- Irish Distillers fined €40,000 following employee fatality
- HSA inspection campaign in March to focus on quarry safety
- HSA launches the Good Practice Awards in conjunction with the European Agency for Safety and Health at Work (EU-OSHA)
- HSA inspection campaign to target transport operations and vehicles at work
- Building company fined €40,000 following death of worker
- Health and Safety Authority Issue Farm Safety Advice Ahead of Silage Season
- HSA publishes safety guidance for seasonal workers in horticulture
- Self-employed Account for Over 50% of work-related fatalities in 2020
- Farm Safety Partnerships urge farmers to ‘rethink risk’
- Farm Safety Partnership launch action plan for 2021 - 2024
- Two Irish companies lead the way in occupational safety and health as they represent Ireland in the European Good Practice Awards
- HSA set to launch two week nationwide inspection campaign in construction sector focusing on the dangers of working at height
- Limerick City and County Council fined €75,000 following the fatal accident of employee
- Quinn Piling Ltd fined €25,000 following fatal incident in Rossaveel Harbour
- Deane Public Works Limited fined €40,000 following employee drowning
- HSA farm inspection campaign to focus on safe working at height
- FVG Construction & Maintenance Ltd fined €50,000 following death of worker
- Wexford company fined €175,000 following death of employee
- Offaly County Council fined €90,000 for breaches of health and safety legislation
- Health and Safety Authority welcomes lowest level of work-related fatalities since records began
- FVG Construction & Maintenance Ltd fined €50,000 following death of worker (1)
-
Press Releases 2020
- Construction deaths increased by 140% in a year when 46 people died in workplace incidents
- HSA farm safety blitz to focus on livestock handling
- HSA launches new traffic management plan for construction sites
- HSA national safety blitz to target transport operations and vehicles at work
- Ennis school children learn how to "Keep Safe" with multi-agency roadshow
- €100,000 fine handed down following asbestos exposure
- Farmer fined after incident on Carlow farm building site
- Company fined €180,000 after incident on Wexford farm building project
- Inspection campaign to highlight need for increased safety awareness on farms
- European Week for Safety and Health at work focuses on Lightening the Load
- 68% of inspections result in enforcement – HSA 2019 Annual Report
- Co. Cork farmer fined €10,000 after death of pipe-laying contractor on his farm
- Axial Properties Ltd fined €80,000 following serious incident in Clonee warehouse
- Doyle Shipping Group fined €850,000 following employee fatality
-
Press Releases 2019
- Figures issued show a 23% decline in work related fatalities in 2018
- HSA inspection campaign to focus on livestock safety
- Company fined €500,000 after fatal accident at Mayo quarry
- Health and Safety Authority campaign to target transport operations and vehicles at work
- Minister Breen launches Health and Safety Authority’s Strategy Statement 2019-21
- Sligo school children learn how to Keep Safe
- Health and Safety Authority farm inspection campaign to focus on tractor and machinery safety
- Charleville school children learn how to "Keep Safe" with multi-agency roadshow
- Oranmore school children learn how to "Keep Safe" with multi-agency roadshow
- Radon in workplaces – new legislation requires employers in high radon areas to test for this cancer-causing gas
- Health and Safety Authority launches free Asbestos for Tradespeople awareness-raising online course
- Carlow school children learn how to "Keep Safe" with multi-agency roadshow
- HSA and Primary School Principals join forces to promote farm safety before high risk summer holiday period
- Company fined €300,000 after fatal pipeline explosion
- Health and Safety Authority (HSA) to drive home tractor safety message at Tullamore Show
- Vehicles are biggest workplace killer in Ireland – HSA annual report
- Inspection Blitz on Dozens of Sites for Quarry Safety Week
- Farmers warned about hidden dangers from confined spaces on farms
- Working at age 55 and over is on the rise in Ireland
- Health and Safety Authority (HSA) warns on danger posed by fallen trees after Storm Lorenzo
- Irish companies warned over threat to chemical supplies in a no-deal Brexit
- Newcastle West school children learn how to ‘Keep Safe’ with multi-agency roadshow
- Brexit-related storage of additional chemicals prompts safety concerns
- HSA construction blitz to target most common workplace illnesses and injuries
- Rush schoolchildren learn how to ‘Keep Safe’ with multi-agency roadshow
- Protecting worker’s Health & Safety is the key to the Workplace of the Future
-
Press Releases 2018
- Elderly farmers most likely to be involved in fatal work related accidents
- Teagasc and HSA renew joint initiative to promote farm safety and health
- Health and Safety Authority farm campaign to focus on Livestock Safety
- HSA publishes details of key priorities and inspection targets for 2018
- HSA launches ‘Under the Sink’ primary school chemical safety resource for children
- Health and Safety Authority urges caution for those returning to work after storm
- New ‘Safety Reps’ course launched online at hsalearning.ie
- Keep Safe road show comes to Letterkenny
- Health and Safety Authority orders products containing restricted chemicals removed from sale
- HSA inspection campaign to target transport operations and vehicles at work
- Keep Safe road show comes to Rathcoole
- Minister Breen marks international day for those injured or killed in the workplace
- Company fined after exposure of employees to Asbestos fibres resulting from demolition works
- Health and Safety Authority campaign to focus on vehicle and machinery safety
- “Keep Safe” road show comes to Ballina school children
- Minister Breen launches new Mine Safety Regulations at Tara Mines
- 50,000 businesses now using free HSA online safety resource
- Health and Safety Authority begins intensive construction safety campaign
- Health and Safety Authority announces appointment of new Chief Executive
- HSA and Primary School Principals join forces to promote farm safety before high risk summer holiday period
- Nenagh school children learn how to “Keep Safe”
- HSA launches Online Construction Safety course for Small Contractors and the Self-Employed
- Health and Safety Authority publishes 2017 Annual Report
- HSA marks 200,000 participants in Choose Safety young people at work programme
- Pat Breen TD, Minister for Trade, Employment and Business, opens HSA exhibit at National Ploughing Championships
- All island farm safety campaign gets under way
- Carlow to host National Farm Safety and Health Conference
- Health and Safety Authority (HSA) campaign to target dangerous substances in construction
- Minister Pat Breen tells national conference, ‘industry-led drives are key to improving farm safety’
- Wexford school children learn how to "Keep Safe"
- Revised Guidelines on Managing Safety, Health and Welfare in Post-Primary Schools issued to all schools
-
Press Releases 2017
- Workplace fatal accidents drop by over 20% during 2016
- HSA publishes work programme and inspection targets for 2017
- New Campaign Highlights Employer Responsibility to Employees who drive for work
- HSA inspection campaign in March to focus on livestock safety
- HSA “Keep Safe” road show comes to Kilkenny school children
- Aer Lingus fined after accident at cargo warehouse
- Concrete product manufacturer fined €1,000,000 for breach of health and safety legislation leading to death of employee
- Workers’ Memorial Day for Ireland to take place on Friday 28th April 2017
- HSA Launches a free chemical safety in the workplace online course
- Dead and injured workers remembered on third Workers’ Memorial Day
- Health and Safety Authority May inspection campaign to focus on tractors and machinery
- Premier Periclase Ltd fined after accident resulting in death of employee
- HSA “Keep Safe” road show comes to Leixlip school children
- HSA to begin inspection campaign to tackle vehicle risks at work
- Health and Safety Authority construction inspection campaign to focus on occupational health
- Company fined after fatal accident at Corrib Gas Tunnel site
- Health and Safety Authority host REACH 10 year anniversary conference
- Keep Safe road show comes to Ballinasloe school children
- Engineering company fined after lift failure
- HSA publishes 2016 Annual Report
- HSA Inspection campaign to focus on chemicals in consumer products
- Pat Breen TD, Minister for Trade, Employment and Business, calls on farmers to get safety training
- Keep Safe road show comes to Listowel
- Health and Safety Authority to begin intensive construction safety campaign
- Health and Safety Authority launches new work related stress campaign
- Health and Safety Authority November inspection campaign to focus on safe working at height
- Kilsaran Concrete ULC fined for safety breach
- Ardee school children learn to ‘Keep Safe’
- Minister Pat Breen calls on stakeholders to intensify efforts to reduce accidents in the sector at National Farm Safety Conference in Ennis
- National conference hears call for employers to focus on occupational health
-
Press Releases 2016
- 55 People killed in work-related accidents in 2015
- Minister Nash Launches Health and Safety Authority “Strategy Statement 2016-18”
- Minister Nash Launches Online Tool for Agribusinesses Aimed at Reducing Accidents and Saving Costs
- Concrete Product Manufacturer Fined €125,000 for Breach of Health and Safety Legislation Leading to Death of Employee
- New Workers Four Times More Likely to Have an Accident
- Cork IT Claim Top Prize in HSA Safety in Undergraduate Construction Competition
- Workers’ Memorial Day for Ireland to take place on Thursday 28th April 2016
- Safe Operation of Machinery a Key Focus for Farm Safety Fortnight
- Dead and Injured Workers Remembered on Second Workers’ Memorial Day
- Cavan Student Wins HSA National Farm Safety Multimedia Award
- V F Cold Stores Ltd Fined €200,000 After Accident Resulting in Death of Employee
- The Health and Safety Authority launches inspection campaign focusing on liquid laundry detergent capsules
- “Keep Safe” Road Show Comes to Offaly School Children
- HSA Launches Free Chemical Safety Online Course for Small Business
- Health and Safety Authority Launches Construction Inspection Campaign Focusing on Occupational Health
- Health and Safety Authority publishes 2015 Annual Report and Statistics Summary
- Three Year Action Plan to Save Lives and Reduce Injuries on Farms Published
- Company Fined €250,000 for Safety Breach
- Construction SMEs Can Reduce Workplace Accidents by Thinking Safety Everyday
- Minister for Employment and Small Business Pat Breen TD Launches Construction Safety Week 2016
- Minister for Jobs, Enterprise and Innovation, Mary Mitchell O’Connor TD, Launches “Safe Stop for Tractors” Initiative
- European Chemicals Agency appoints Irish Chemicals Expert as Chair of Management Board
- Keep Safe Road Show Comes to Meath School Children
- New Campaign Focuses on Europe’s Ageing Workforce
- National Farm Safety Conference 2016
- HSA launches free ‘Managing Driving for Work’ online course
- Keep Safe Road Show Comes to Mayo School Children
- Kildare County Council and Astellas Pharma to represent Ireland in EU safety and health competition
- HSA Inspection Campaign Focuses on Banned and Restricted Chemicals
- Minister Voices Alarm at Spike in Farm Deaths
- Managing Workplace Bullying Complaints
-
Press Releases 2015
- 55 people killed in work related accidents during 2014
- Health and Safety Authority Publishes 2015 Programme of Work
- Transport Company Fined for Safety Breach
- New Workplace Vehicle Safety Campaign from the HSA
- Company Fined for Construction Design Failure that Led to Stairs Collapse
- Institute of Technology Carlow wins HSA Third Level ‘Safety in Construction’ Third Level Competition
- ESB Fined After Accident Resulting in Death of Employee
- Parents and Childminders Urged to be Aware of Dangers of Detergent Liquid Capsules to Children
- Minister Nash Announces National Day of Action to Mark Workers’ Memorial Day Ireland
- Ministers Coveney and Nash Join Farm Walk to Promote Safety
- Keep Safe Roadshow Comes to Carlow School Children
- Keep Safe Roadshow Comes to Newtownmountkennedy School Children
- Dead and Injured Workers Remembered on Workers’ Memorial Day Ireland
- Free HSA ‘Farm Safely with Slurry’ Short Course Now Available Online
- Keep Safe Road Show Comes to Gort
- HSA Launches Free On-line Health and Safety Courses on Work-related Vehicle Safety
- Minister Nash Launches Online Tool for Construction Aimed at Reducing Accidents and Achieving Cost Savings of up to €18m
- Keep Safe Roadshow Comes to Newtownforbes School Children
- HSA Asks Primary Schools to Deliver the Farm Safety Message Before High Risk Summer Holidays Begin
- Irish Ferries Fined after Man Crushed to Death
- Health and Safety Authority publishes Annual Report and Statistics Summary for 2014
- HSA Launches Free ‘Slips, Trips and Falls’ Online Course
- Health and Safety Authority launches construction inspection campaign
- Minister for Business and Employment Ged Nash TD launches “Safe use of Tractors and Machinery on Farms” Guidance Document
- Local Businesses Urged to Proactively Manage Workplace Mental Health
- Health and Safety Authority Launches National Farm Safety Multimedia Competition for Post-Primary Students
- Positive Working Environment a Key Factor in Organisational Success
- All-Island Conference on Farm Safety Takes Place in Co. Monaghan
- 'Building is Hard - Rebuilding is Harder' - HSA Launches New Awareness Raising Campaign Aimed at the Construction Sector
- Minister for Business and Employment Ged Nash TD launches “Code of Practice for Health and Safety in Dock Work”
- ‘Grandad Built Our House’ – Minister Nash Launches HSA-sponsored Children’s Book to Raise Awareness in High Risk Construction Sector
-
Press Releases 2014
- 46 people lose their lives due to workplace accidents in 2013
- St. Angela’s College nursing team take first prize in HSA health and safety in healthcare competition
- Inspections of high risk sectors and support for SME sector key themes in 2014
- NUI Galway wins HSA Third Level ‘Safety in Construction’ competition
- Presentation Tralee pupils present findings of household chemical safety project to Health and Safety Authority
- Castlebar school children learn to ‘Keep Safe’
- Fishermen up to 40 times more likely to be killed at work
- Workplace leaders and managers urged to manage stress and psychosocial risks
- Concern at high number of workplace fatalities occurring in Cork
- Minister for Agriculture launches new slurry safety DVD
- HSA urges safety with chemicals on World Day for Safety and Health at Work
- HSA recognises Young Social Innovators on farm safety in bid to tackle farm deaths
- HSA Launches Free Health and Safety Courses Online
- “Keep Safe” Road Show Comes to Portlaoise School Children
- Ministers Bruton and Coveney Join HSA & IFA in Safety Call to Farmers
- Employers Urged to be Extra Vigilant with Young Workers on Summer Jobs
- 12 Month Countdown to CLP Compliance Begins Today
- Health and Safety Authority Inspections Blitz to focus on Construction Sector in Cork
- “Keep Safe” Road Show Comes to Mullingar School Children
- HSA Launches Free Online Health & Safety Courses for Healthcare Managers
- Company and Plant Foreman Fined for Safety Breaches Resulting in Man’s Death
- Two Companies Fined for Safety Breaches Resulting in Fatal Fall
- Farm families to take part in first ‘National Farm Safety Awareness Day’
- Health and Safety Authority Publishes Annual Report and Statistics Summary
- National Conference Hears how to Implement Safety Behaviour Change in Agriculture
- Health and Safety Authority to Begin Intensive Construction Safety Campaign
- Health and Safety Authority, An Garda Síochána and the Road Safety Authority Join to Focus on Tractor Safety
- Up to 1,000 Lives Saved Since the Establishment of the Health and Safety Authority 25 Years Ago
- HSA Launches Annual Competition for Nursing Undergraduates with Focus on Psycho-social Risks
- Health and Safety Authority Urges Clonmel School Children to “Keep Safe”
- HSA Announces Annual Construction Competition for Third Level Construction Undergraduates
- Cross Border Construction Safety Seminar Hears Call for Increased Standards
- European Week for Safety and Health at Work
- Community Service Ordered for Accident that Resulted in the Death of a Bar Worker
- Keep Safe Roadshow Comes to Monaghan School Children
- ‘Too Cold for Sharks’ - Ministers Launch HSA-Sponsored Children’s Book to Raise Awareness in High Risk Fishing Sector
- Minister for Business and Employment Gerald Nash TD Launches Guidance for “Managing Health and Safety in Fishing”
-
Press Releases 2013
- 13 percent decrease in number of workplace deaths during 2012
- Safety on farms a priority as Minister Bruton launches new HSA Strategy and Programme of Work
- The European Chemicals Agency (ECHA) launches the Classification and Labelling Platform
- First Keep Safe event of 2013 hosted in Kilkenny
- Company fined 1 Million Euro for accident that resulted in the death of 2 members of the public
- IT Carlow team wins HSA National Safety in Windfarm Construction Competition
- Minister Sherlock urges Irish industry to take advantage of opportunities under EU chemicals legislation
- HSA & IFA join forces to launch farm safety campaign
- Athlone IT teams win first and second place in HSA Health and Safety in Healthcare Competition
- Health and Safety Authority launches ‘On the Farm’ primary schools' publishing competition to raise awareness of child safety on farms
- Minister Bruton: Balance between worker protection and business growth vital to sustained long term commercial success
- Keep Safe roadshow comes to Waterford
- Minister Bruton launches HSA Annual Report and Statistics Summary
- Employers urged to be extra vigilant with young workers on summer jobs
- Implementing Controls the Key to Farm Safety Progress
- Survey to Explore what Factors Influence Farm Safety
- HSA urging employers to make employees aware of summer driving hazards
- Company fined in relation to fatal school bus accident
- Farmers are asked to ‘Stay Fit for Farming’
- Close collaboration between managers and workers key to reducing workplace accidents
- Wicklow County Council fined €355,000
- Drummonds Ltd. fined €125,000 after death of two workers in grain silo
- HSA launches new safety and health management resource for primary schools
- Common misperceptions tackled in new HSA campaign
- ‘Only a Giant Can Lift a Bull!’ - Minister launches HSA sponsored children’s farm safety book
-
Press Releases 2025
- Media Campaigns
-
Press Releases 2013 to 2025
-
Events
-
About Us
- Board
- Organisational Structure
- Vision and Mandate
- Values
- Public Consultation
-
Public Sector Information
-
Prompt Payment Details
- Prompt Payment Details October - December 2025
- Prompt Payment Details July - September 2025
- Prompt Payment Details April - June 2025
- Prompt Payment Details January - March 2025
- Prompt Payment Details October - December 2024
- Prompt Payment Details July - September 2024
- Prompt Payment Details April - June 2024
- Prompt Payment Details January - March 2024
- Prompt Payment Details October - December 2023
- Prompt Payment Details July - September 2023
- Prompt Payment Details April - June 2023
- Prompt Payment Details January - March 2023
- Prompt Payment Details October - December 2022
- Prompt Payment Details April - June 2022
- Prompt Payment Details January - March 2022
- Prompt Payment Details October - December 2021
- Prompt Payment Details July - September 2021
- Prompt Payment Details April - June 2021
- Prompt Payment Details January - March 2021
- Prompt Payment Details October - December 2020
- Prompt Payment Details July - September 2020
- Prompt Payment Details April - June 2020
- Prompt Payment Details October - December 2019
- Prompt Payment Details January - March 2020
- Prompt Payment Details July - September 2019
- Prompt Payment Details April - June 2019
- Prompt Payment Details January - March 2019
- Prompt Payment Details October - December 2018
- Prompt Payment Details July - September 2018
- Prompt Payment Details April - June 2018
- Prompt Payment Details January - March 2018
- Prompt Payment Details October - December 2017
- Prompt Payment Details July - September 2017
- Prompt Payment Details April - June 2017
- Prompt Payment Details January - March 2017
- Prompt Payment Details October - December 2016
- Prompt Payment Details July - September 2016
- Prompt Payment Details April - June 2016
- Prompt Payment Details January - March 2016
- Prompt Payment Details October - December 2015
- Prompt Payment Details July - September 2015
- Prompt Payment Details April - June 2015
- Prompt Payment Details January - March 2015
- Prompt Payment Details October - December 2014
- Prompt Payment Details July - September 2014
- Prompt Payment Details April - June 2014
- Prompt Payment Details January- March 2014
- Prompt Payment Details October - December 2013
- Prompt Payment Details July - September 2013
- Prompt Payment Details April - June 2013
- Prompt Payment Details Jan - March 2013
- Prompt Payment Details Oct - Dec 2012
- Prompt Payment Details July - Sept 2012
- Prompt Payment Details April - June 2012
- Prompt Payment Details Jan- March 2012
- Prompt Payment Details October - December 2011
- Prompt Payment Details July - September 2011
-
Purchase Orders in Excess of €20,000
- Purchase Orders in excess of €20,000 Jan-Jun 2016
- Purchase Orders in Excess of €20,000 Q3 2016
- Purchase Orders in Excess of €20,000 Q4 2016
- Purchase Orders in Excess of €20,000 Q1 2017
- Purchase Orders in Excess of €20,000 Q2 2017
- Purchase Orders in excess of €20,000 Q3 2017
- Purchase Orders in excess of €20,000 Q4 2017
- Purchase Orders in excess of €20,000 Q1 2018
- Purchase Orders in Excess of €20,000 Q2 2018
- Purchase Orders in Excess of €20,000 Q3 2018
- Purchase Orders in Excess of €20,000 Q4 2018
- Purchase Orders in Excess of €20,000 Q1 2019
- Purchase Orders in Excess of €20,000 Q2 2019
- Purchase Orders in Excess of €20,000 Q3 2019
- Purchase Orders in Excess of €20,000 Q4 2019
- Purchase Orders in Excess of €20,000 Q1 2020
- Purchase Orders in Excess of €20,000 Q2 2020
- Purchase Orders in Excess of €20,000 Q4 2020
- Purchase Orders in Excess of €20,000 Q3 2020
- Purchase Orders in Excess of €20,000 Q2 2021
- Purchase Orders in Excess of €20,000 Q1 2021
- Purchase Orders in Excess of €20,000 Q3 2021
- Purchase Orders in Excess of €20,000 Q4 2021
- Purchase Orders in Excess of €20,000 Q1 2022
- Purchase Orders in Excess of €20,000 Q2 2022
- Purchase Orders in Excess of €20,000 Q3 2022
- Purchase Orders in Excess of €20,000 Q4 2022
- Purchase Orders in Excess of €20,000 Q1 2023
- Purchase Orders in Excess of €20,000 Q2 2023
- Purchase Orders in Excess of €20,000 Q3 2023
- Purchase Orders in Excess of €20,000 Q4 2023
- Purchase Orders in Excess of €20,000 Q1 2024
- Purchase Orders in Excess of €20,000 Q2 2024
- Purchase Orders in Excess of €20,000 Q3 2024
- Purchase Orders in Excess of €20,000 Q4 2024
- Purchase Orders in Excess of €20,000 Q1 2025
- Purchase Orders in Excess of €20,000 Q2 2025
- Purchase Orders in Excess of €20,000 Q3 2025
- Financial Statements and Reports
-
Prompt Payment Details
- Regulation of Lobbying
- Contact Us
- Customer Service